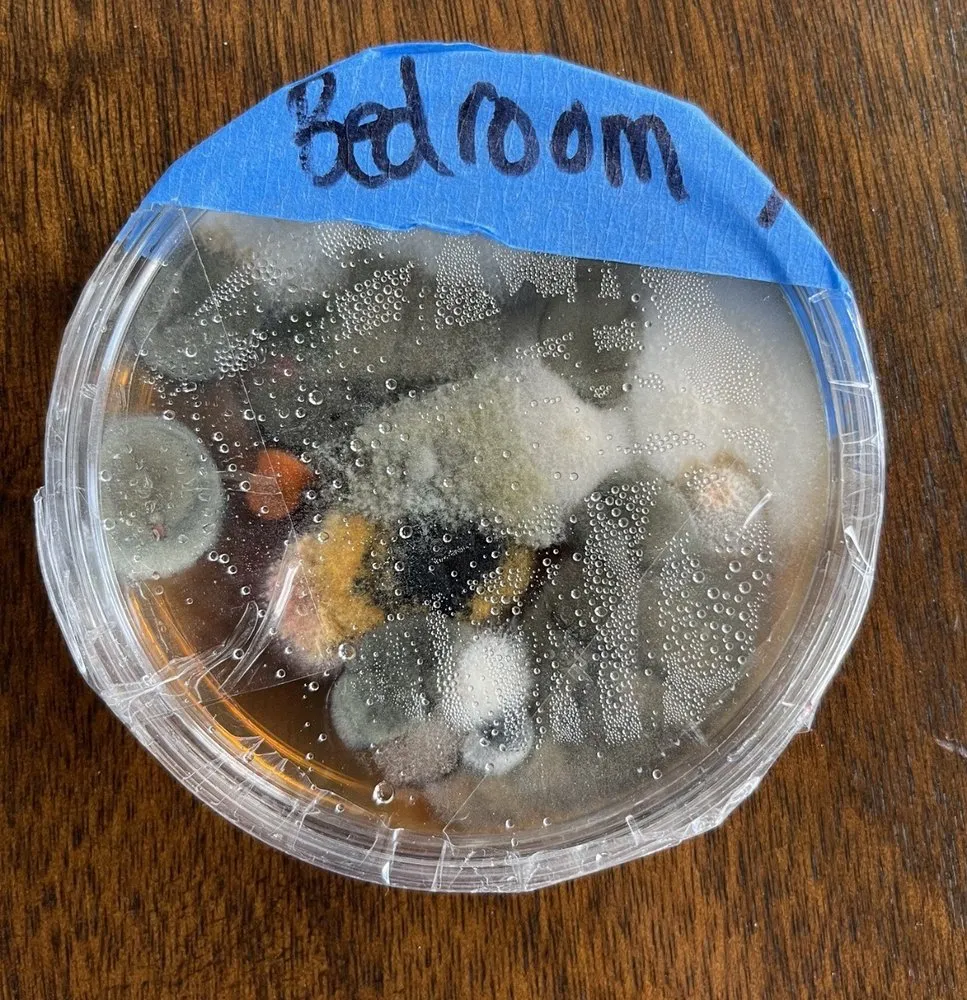
Slide of Lang 72 Degrees

Lang 72 Degrees: Your Bluffton SC HVAC Experts Since 1976
About Lang 72 Degrees
Lang 72 Degrees is a family-owned heating and cooling company based right here in Bluffton, South Carolina. For over four decades, they have been the go-to HVAC experts for homeowners across the Lowcountry. The team offers 24/7 emergency service with a strong same-day guarantee. If a repair isn't done right the first time, you won't pay for it. Their staff includes NATE certified technicians, which means they are trained to handle any system.
Their work focuses mainly on residential properties, helping families stay comfortable year-round. From historic Beaufort homes to new builds on Hilton Head, they understand local needs.
Key Services
Lang 72 Degrees provides a full range of HVAC solutions for your home. Their main services include:
- HVAC Installation or Replacement: Whether you need a new system for a renovation or your old unit has finally quit, they handle the entire process.
- HVAC System Repair: They fix all makes and models, often on the same day you call.
- HVAC System Maintenance: Regular tune-ups can prevent breakdowns during our hot, humid summers or our occasional chilly winters.
- Air Duct Cleaning & Air Quality: This service helps reduce allergens and improve airflow, which is important in our coastal climate.
Areas Served
Lang 72 Degrees proudly serves communities throughout South Carolina's Lowcountry. You'll find their trucks in:
- Hilton Head Island SC & Hilton Head SC
- Bluffton SC
- Beaufort SC, Port Royal SC, & Burton SC
- Laurel Bay SC & Hardeeville SC
- Ridgeland SC & Shell Point SC
- Estill SC, Seabrook SC, & Edisto Beach SC
They know the common HVAC issues in our area's older homes and modern buildings. This local knowledge helps them diagnose problems faster.
Company History
The business was founded in 1976. It started as a small, local operation focused on honest service. Over the years, Lang 72 Degrees in Bluffton SC grew by sticking to a simple idea: treat every customer like family. They've built long-term relationships with residents and have adapted to new technologies while keeping their core values.
Leadership
As a family-run company, the owners are involved in daily operations. They live and work in the community, so their reputation matters. Their team members often participate in local programs, supporting the area they serve. This local presence means they are invested in your comfort.
Specialties & Highlights
Several things make Lang 72 Degrees stand out:
- Carrier Factory Authorized Dealer: They offer high-quality, reliable Carrier equipment.
- NATE Certified Technicians: This certification means advanced training and knowledge.
- 24/7 Service with a Same-Day Guarantee: You won't be left sweating or shivering for long.
- Family-Owned Since 1976: Decades of experience serving Bluffton SC and the surrounding towns.
- Residential Focus: They specialize in home systems, not large commercial projects.
Why Locals Choose Lang 72 Degrees
People in the Lowcountry choose Lang 72 Degrees for reliability and quality. They have been here since 1976, so they understand our weather and homes. Their same-day guarantee shows confidence in their work. When you need HVAC installation, repair, or maintenance in Bluffton SC, they provide straightforward service from a team you can trust.
Contact Information
Lang 72 Degrees
: 25 Kitties Landing Rd, Bluffton, SC 29910
: http://www.langsheatingandair.com/
Business Services
- HVAC installation or replacement
- HVAC system repair
- HVAC system maintenance
Business Location & Hours
| Mon: | Open 24 hours |
| Tue: | Open 24 hours |
| Wed: | Open 24 hours |
| Thu: | Open 24 hours |
| Fri: | Open 24 hours |
| Sat: | Open 24 hours |
| Sun: | Open 24 hours |